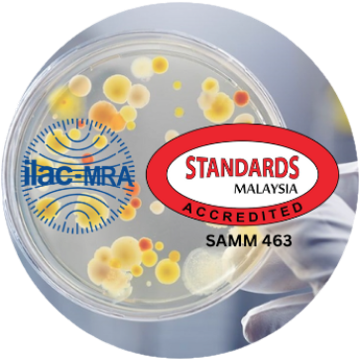

About Us
KHTP Bio Analytical Laboratory Sdn. Bhd.
, a subsidiary of Kulim Technology Park Corporation (KTPC), was originally established in 2006 under the name Kedah BioResources Corporation Sdn. Bhd. In 2023, it was rebranded as KHTP Bio Analytical Laboratory Sdn. Bhd. to strengthen its positioning and brand identity.
Strategically located within Kulim Hi-Tech Park (KHTP), Kedah,
provides world-class laboratory testing and analytical services. Our comprehensive solutions support industries in ensuring quality, compliance, and safety across diverse sectors, including Occupational Health & Industrial Hygiene, Environmental, Medical Devices, Food & Beverages, Cosmetics & Herbs, Agriculture, and Animal Feed.
In addition,
extends its expertise through Training & Consultancy services, equipping industries with knowledge and best practices to achieve operational excellence.
With advanced facilities, accredited capabilities, and a team of dedicated experts,
is committed to delivering reliable, accurate, and trusted results – empowering businesses to achieve excellence in a competitive global market.

Milestone
Mission and Vision
Vision
To be a preferred laboratory for analytical testing in Malaysia
Mission
To provide analytical services that meets:
Corporate Structure

Acknowledgement
Accreditation & Professional Registration